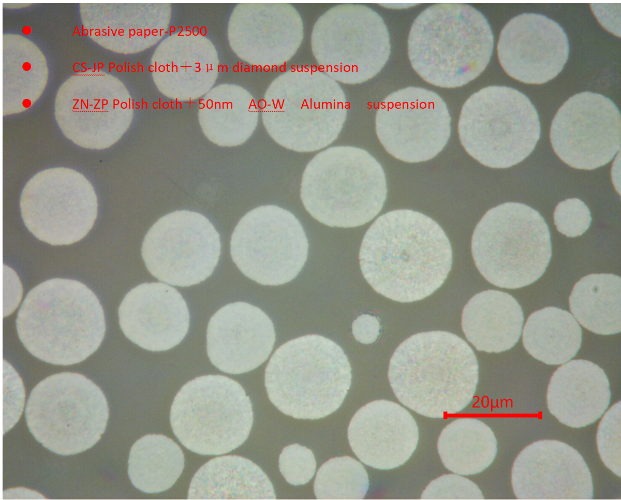

ภายใต้แรงกดดันคู่ของการขาดแคลนพลังงานและการป้องกันสิ่งแวดล้อมทั่วโลกแบตเตอรี่ลิเธียมที่มีความหนาแน่นพลังงานสูงและอายุการใช้งานที่ยาวนานได้กลายเป็นตัวเลือกหลักในด้านการจัดเก็บพลังงานและพลังงาน จากระบบจัดเก็บพลังงานของสถานีพลังงานโทรคมนาคมและการสื่อสารแหล่งจ่ายไฟที่ไม่หยุดยั้งไปจนถึงยานพาหนะไฟฟ้าอุปกรณ์การทหารและอวกาศและอวกาศขอบเขตการใช้งานของแบตเตอรี่ลิเธียมยังคงขยายตัว
ในองค์ประกอบของแบตเตอรี่ลิเธียม-ไอออนที่ประกอบไปด้วยวัสดุแคโทดมีบทบาทอย่างเด็ดขาดในประสิทธิภาพของแบตเตอรี่และการเตรียมผงสารตั้งต้นที่มีคุณภาพสูงเป็นขั้นตอนแรกในการรับวัสดุแคโทดคุณภาพสูง อย่างไรก็ตามเพื่อประเมินคุณภาพและประสิทธิภาพของผงสารตั้งต้นแบบไตรมาสอย่างถูกต้องการเตรียมโลหะเป็นขั้นตอนสำคัญที่ขาดไม่ได้ ต่อไปนี้เป็นขั้นตอนวิธีการเตรียมตัวอย่างสำหรับการอ้างอิงของคุณ
① P2500 การบดกระดาษทราย metallographic
② CS 3μm PD-WT Solition Polishing Polishing Polishing
③ Zn 0.05μm AO-W Alumina Polishing Solution Polishing